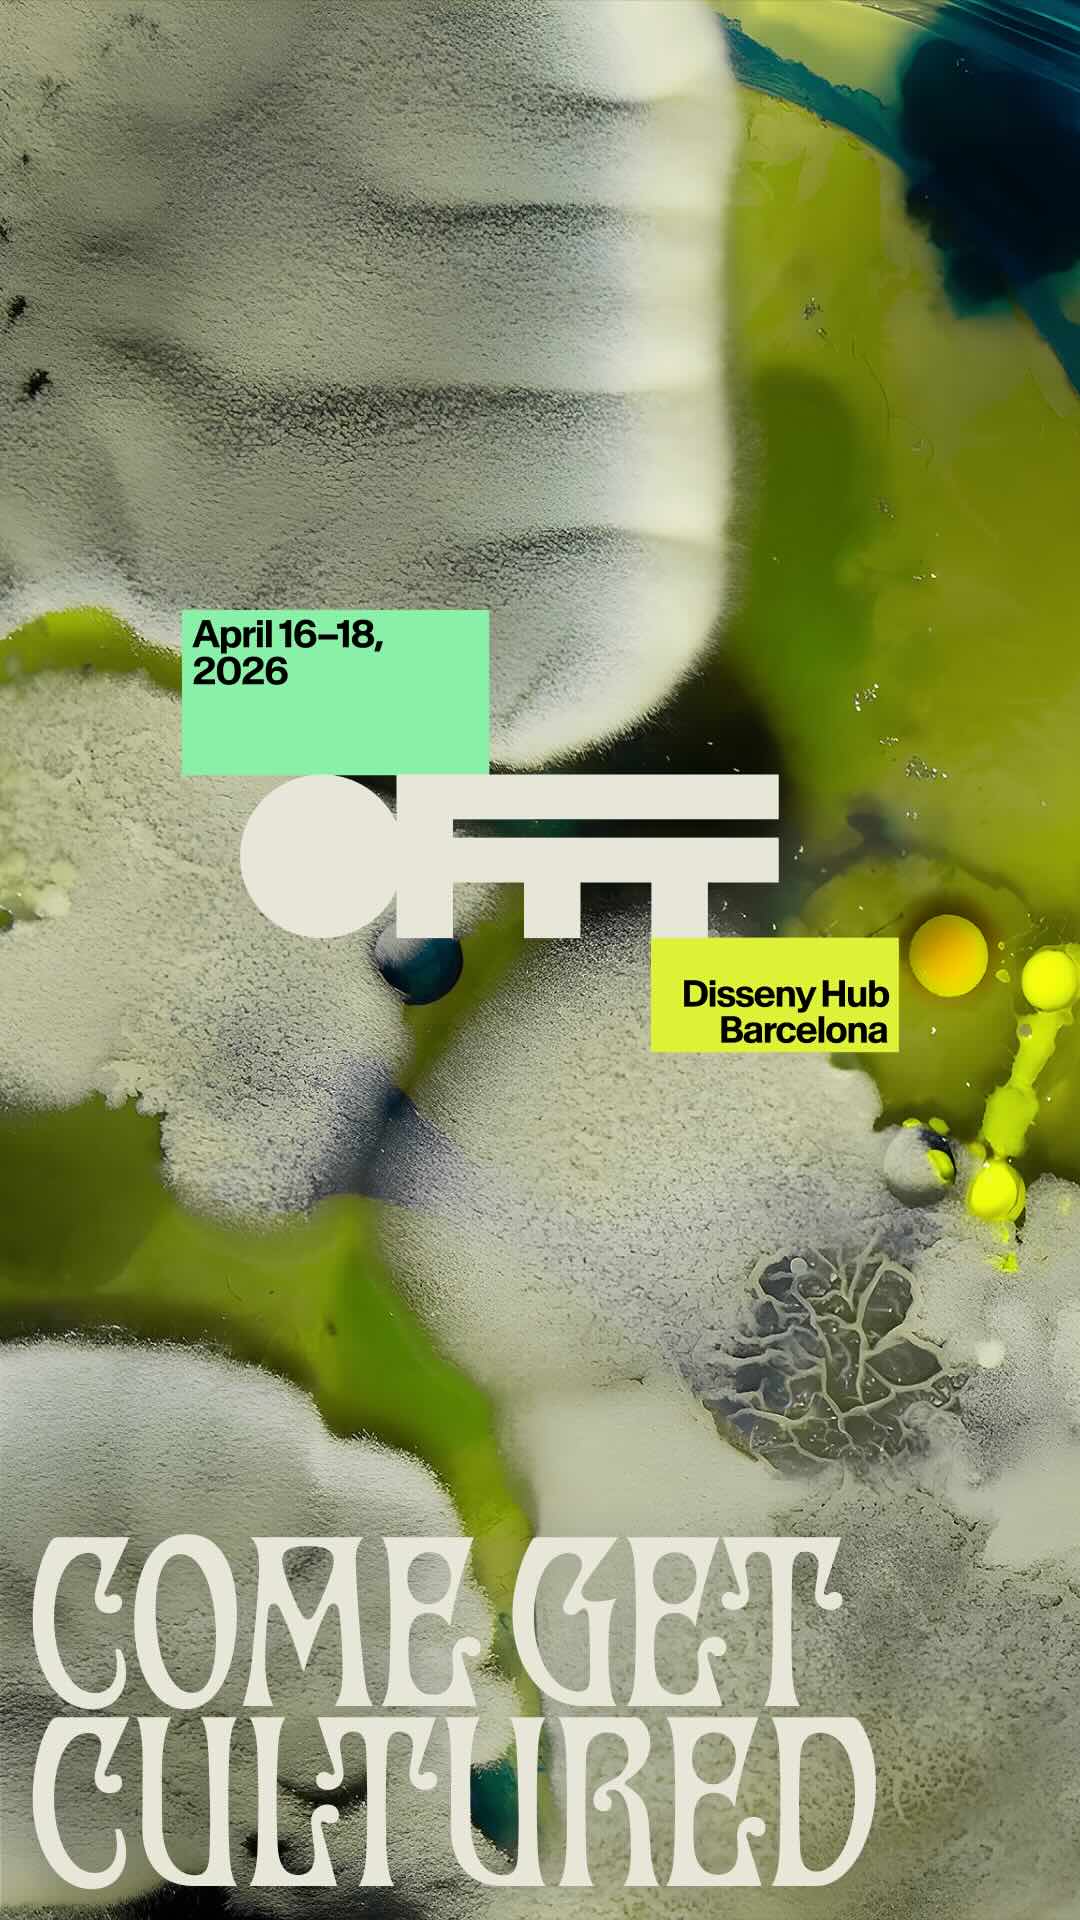

文化はあたかも人々によって形成された生きた生態系であるかのように、広がり、変化し、進化するという考えが、バルセロナ版の広告キャンペーンを明確に表現しています。 オフは、4 月 16 日から 18 日まで開催された創造性、アート、デジタル デザインの国際フェスティバルです。 アンコモン クリエイティブ スタジオは、クリエイティブ コミュニティの生物学的素材を使用して、ビジュアル ユニバース全体に命を吹き込むことで、コンセプトを最大限に表現します。
卒業 「私たちが作るもの」、 このキャンペーンは、少数ではなく多くの人々のアイデア、参照、視点の交換の結果として文化を探求します。そしてそれは、人生そのものと同じように、適切な協力条件下で起こります。フェスティバルの主催者は、イベント自体が表すものと並行して、コラボレーションは結果ではなく方法であるということを伝えようと努めてきました。そして、心を一つにして話したり実験したりすると、世界の新しい見方や理解の仕方が生まれるということです。
そのビジョンを表現し、会議のグラフィックアイデンティティを形成するために、化学研究の世界が政府機関によって選ばれました。 実験材料と生物培養 クリエイティブなコミュニティそのものから引き出され成長しています。アンコモンが説明したように、彼らはロンドンとニューヨークのスタジオにこの分野の専門家を招待し、一連のセッションを行った。そこではアイデアを共有することに加えて、ドアノブやカップから指紋、繊維、液体を収集してデザインシステムに落とし込んだという。
収集されたサンプルは、 「バイオアーティスト」ダーシャ・プレセン、細菌を芸術の素材として使用するため、「カビの女王」としても知られています。実験室の設備で増殖したこれらの細菌は、これまでに作られた一連の形状、質感、パターンの基礎となってきました。 カラーパレットと組み合わせて 創造的なコミュニティの多様性、予測不可能性、活力を反映する視覚的言語を作成するために、自然の最も鮮やかな色調からインスピレーションを受けています。
この耕された生きた生態系は、このイベントがソーシャル ネットワークやその他のメディアを通じて宣伝してきた印象的なグラフィック作品の主人公です。ポスターにはOFFFのロゴ、日付と会場、主張が記載されていました。 「文化を学びに来てください」、「栽培する」と「文化化する」という用語の間の言葉遊びです。
さらに、フェスティバルのロゴがペトリ皿の形をした作品も作成され、クリエイティブなコミュニティがその提案の枠組みの中で発展し成長するという考えを強化しています。
「Hyphae」と呼ばれるキャンペーンのタイポグラフィは、キャンペーンの創造的なコンセプトに沿った実験的で生物形態的な文字の形からインスピレーションを得ています。 モダニズム、 19 世紀末から 20 世紀初頭にかけてバルセロナで大きな存在感を示した文化運動。
それは、ソーシャルネットワークからプログラムの議題、部屋の装飾に至るまで、フェスティバルのあらゆる接点で見られました。
さらに、とのコラボレーションによるビジュアルシステムも実現。 ハルプロジェクト陶芸工房、バルセロナでの今回のフェスティバルの講演者と講演者のために100枚のセラミックペトリ皿を作成しました。
「What We Make It」では、 人間の才能がメッセージの中心にある そして、キャンペーンが彼らに向けられたものではなく、彼らから生まれたものであることを専門家に伝えます。このフェスティバルは、作家性と創造的な交流とコラボレーションの力を祝うものであると主張しています。そして、人工知能が存在感を増し、ますます短命な市場において、この業界は人々で構成されており、その未来は共に築くことができるということを伝えています。